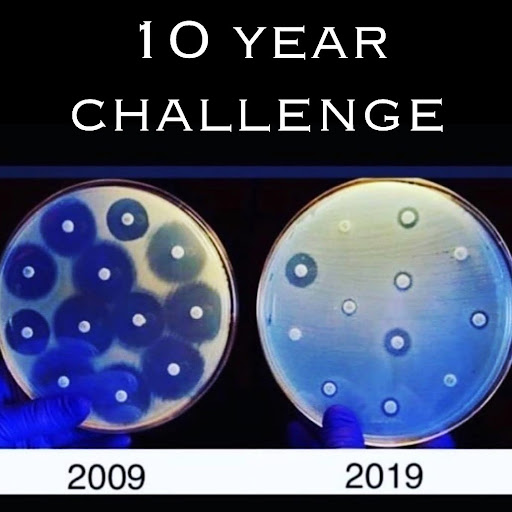

Desde nuestro nacimiento hasta nuestra muerte, las bacterias nos acompañarán e incluso formarán parte de nuestro organismo compartiendo múltiples procesos, espacio, recursos y nutrientes. Algunas bacterias nos ayudan con algunos procesos, otras son dañinas desde el primer contacto, y otras se mantienen expectantes para aprovechar la oportunidad que se les ofrezca para atacar. Estas dos últimas clases pueden generar una gama de enfermedades de fácil a difícil tratamiento (1).
Ante ello, el ser humano ha desarrollado terapias farmacológicas para ganar esta guerra contra los microorganismos, sin embargo, las bacterias han contraatacado y hoy en día la resistencia que han desarrollado es un problema de salud pública, cuyo crecimiento es alarmante y genera varios riesgos como: tratamientos ineficaces, enfermedades con cuadros extremadamente graves, y un aumento en los costos hospitalarios y en las tasas de morbilidad y mortalidad (2).
Esta resistencia bacteriana es definida por la OMS como la capacidad de las bacterias de sobrevivir a los efectos de los antibióticos (3). La resistencia a los antimicrobianos puede ser intrínseca, es decir, propio o natural de la especie o familia bacteriana o puede ser adquirida y adaptada mediante modificaciones de los genes bacterianos (4).
Reygaert en su artículo “An overview of the antimicrobial resistance mechanisms of bacteria” explica los orígenes de la resistencia mencionando que aquella natural puede estar siempre presente en el microorganismo o activar los genes de protección luego del contacto con el antimicrobiano (4).
| ORGANISMO | RESISTENCIA INTRÍNSECA |
|---|---|
| Bacterias grampositivas | Aztreonam |
| Bacterias gramnegativas | Glucopéptidos, lipopéptidos. |
| Enterococos | Aminoglucósidos, Cefalosporinas, lincosamidas. |
| Listeria monocytogenes | Cefalosporinas |
| Escherichia Coli | Macrólidos |
| Klebsiella spp. | Ampicilina. |
| Serratia marcescens | Macrólidos. |
| Pseudomonas aeruginosa | Sulfonamidas, ampicilina, cefalosporinas de 1ra y 2da generación, tetraciclina. |
| Acinetobacter spp. | Ampicilina, glucopéptidos. |
Modificado por: Paola Quichimbo.
La resistencia adquirida, por su parte se entiende como el desarrollo de varios mecanismos o factores que le confieren a una bacteria, antes sensible a un determinado antibiótico, inmunidad contra este (2).
Mecanismos de resistencia bacteriana:

Inactivación enzimática: se trata de la producción de enzimas específicas por parte de las bacterias, las cuales van a destruir e inactivar el antibiótico (5). Hoy en día, destacan entre estas enzimas, las betalactamasas producidas por bacterias gramnegativas como el Staphylococcus aureus, las KPC (Klebsiella Pneumoniae Carbapenemasa) y las enzimas NDM (Nueva Delhi Metalo beta-lactamasas), encontradas por primera vez en la bacteria Klebsiella pneumoniae y que actualmente su resistencia se ha extendido a otras especies bacterianas. Las enzimas BLEE (β-lactamasas de espectro extendido) producidas principalmente por Escherichia coli, presentan una acción realmente preocupante, pues son cada vez menos los antimicrobianos que se pueden utilizar ante cuadros clínicos derivados de bacterias productoras de este tipo de enzimas (1).

Modificaciones en la permeabilidad: consiste en un cambio en la permeabilidad de la pared bacteriana frente a la acción del fármaco, de modo que este no puede ingresar y por tanto se genera un fallo farmacológico. Para generar este mecanismo de protección las bacterias generan cambios en el diámetro y en el número de porinas, lo que impide el paso de las sustancias farmacológicas (4).
Modificación del sitio activo: las bacterias alteran el sitio blanco mediante la modificación del gen que codifica el sitio de acción del antimicrobiano. Las más conocidas son las modificaciones en el gen MecA que codifica para las PBP (proteínas fijadoras de penicilina). Un aumento en las PBP, disminuye o directamente inhibe la capacidad de unión del fármaco con la pared bacteriana impidiéndole realizar la acción (4).
Actualmente, se ha descrito resistencia a la vancomicina en Enterococos VR (resistentes a la vancomicina) y en Staphylococcus aureus MRSA (resistente a la meticilina), la cual se genera a partir del paso de genes que reestructuran a los precursores de peptidoglicanos, alterando la pared bacteriana y ocasionando una incapacidad de unión bacteria-vancomicina (1).
Bombas de eflujo o expulsión: Las bacterias expulsan los fármacos de su interior mediante transportadores o bombas de salida (6). Las bombas de eflujo se clasifican en cinco grupos o familias de acuerdo a su estructura, y estos son, el grupo de pequeñas resistencias a múltiples fármacos (SMR), grupo de casetes de unión a ATP (ABC), grupo de división celular de nodulación de resistencia (RND), grupo de extrusión de compuestos tóxicos y multifármacos (MATE), y la principal superfamilia facilitadora (MFS) (4).
Resistencia cruzada
La resistencia antimicrobiana cruzada hace referencia al fenómeno que ocurre cuando las bacterias que son resistentes a un determinado tipo de fármaco, también son resistentes a otros medicamentos químicamente semejantes o cuyo mecanismo de acción es similar. Podemos mencionar a algunos aminoglucósidos, macrólidos, lincosamidas o tetraciclinas (7).

En base a lo ya mencionado, se supone que los mecanismos de resistencia bacteriana son cada vez más específicos, versátiles y adaptativos, lo que es sin duda preocupante, pues en algunos años, ciertas enfermedades bacterianas muy simples de tratar, constituirán próximas pandemias de difícil control.
De este modo, en esta guerra que inició hace cientos de años, las bacterias van ganando. Las perspectivas para el uso de antibióticos tradicionales no son muy positivas, sin embargo, lo que podemos hacer hasta desarrollar nuevos y mejorados antimicrobianos, es evitar el desarrollo de estas resistencias, siendo muy selectivos con los antibióticos empleados de acuerdo al cuadro clínico y a la dosificación exacta.
Referencias:
- Riedel S, Hobden J, Miller S, Morse S, Mietzner T, Detrick B, Mitchell T, Sakanari J, Hotez P, Mejia R. Jawetz, Melnick & Adelberg. Farmacoterapia antimicrobiana, Microbiología Médica, 28e. China: McGraw-Hill; 2019. 363-396
- Resistencia a los antimicrobianos – OPS/OMS | Organización Panamericana de la Salud [Internet]. Paho.org. 2021 [citado 24 julio 2021]. Disponible en: https://www.paho.org/es/temas/resistencia-antimicrobianos
- World Health Organization. Antibiotic resistance [Internet]. Who.int. 2020 [citado 24 julio 2021]. Disponible en: https://www.who.int/news-room/fact-sheets/detail/antibiotic-resistance
- Reygaert WC. An overview of the antimicrobial resistance mechanisms of bacteria. [Internet]. AIMS Microbiol. PMC. 2018 [citado 24 julio 2021]. Disponible en: https://www.ncbi.nlm.nih.gov/pmc/articles/PMC6604941/
- Resistencia antimicrobiana: microorganismos más resistentes y antibióticos con menor actividad [Internet]. Revista Médica De Costa Rica y Centroamérica LXXIII. 2016 [citado 24 julio 2021]. Disponible en: https://www.binasss.sa.cr/revistas/rmcc/621/art03.pdf
- Jerez D, Sánchez R, Montagut L. Identificación del gen mdfA de bomba de eflujo en aislamientos de Escherichia coli intestinales en una población pediátrica de Bucaramanga y su área metropolitana. [Internet]. Repositorio.udes. Universidad de Santander. 2019 [citado 24 julio 2021]. Disponible en: https://repositorio.udes.edu.co/bitstream/001/4459/1/Identificaci%C3%B3n%20del%20gen%20mdfA%20de%20bomba%20de%20eflujo%20en%20aislamientos%20de%20Escherichia%20coli%20intestinales%20en%20una%20poblaci%C3%B3n%20pedi%C3%A1trica%20de%20Bucaramanga%20y%20su%20%C3%A1rea%20metropolitana.pdf
- Díaz C, Vásquez K. Resistencias bacterianas en muestras de pacientes hospitalizados en el Instituto De Seguridad Social José Carrasco Arteaga. [Internet]. Dspace.ucuenca.edu.ec Universidad de Cuenca. 2018 [citado 24 julio 2021]. Disponible en: https://dspace.ucuenca.edu.ec/bitstream/123456789/29744/1/PROYECTO%20DE%20INVESTIGACI%c3%93N.pdf